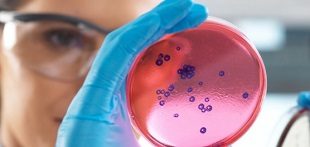

ADDIS ABABA | Xinhua | The 2025 General Assembly of the China-Africa Agricultural Science and Technology Innovation Alliance (CAASTIA) kicked off on Monday in Addis Ababa, Ethiopia’s capital, with a focus on cooperation for Africa’s food security and agricultural modernization. President of the African Academy of Sciences Lise Korsten said …
Read More »Experts warn of Africa’s surging environmental crimes
NAIROBI, KENYA | Xinhua | A spike in environmental crimes in Africa is threatening peace, stability and sustainable development, experts said Monday on the sidelines of the 20th session of the African Ministerial Conference on the Environment in Nairobi, the Kenyan capital. Ababu Namwamba, Kenya’s permanent representative to the United …
Read More »Experts: Uganda must continue anti-money laundering reforms
Reports estimate that trade-based money laundering costs Uganda over $6.6 billion annually Kampala, Uganda | JULIUS BUSINGE | Financial experts have called for sustained collaboration between Uganda’s public and private sectors to strengthen the country’s anti-money laundering (AML) framework, following its recent removal from the Financial Action Task Force (FATF) Grey …
Read More »Telecom experts push for lower cross-border call charges in Africa
The workshop urged regional governments to accelerate policy alignment to extend affordable mobile services to all member states Kampala, Uganda | THE INDEPENDENT | Telecommunications experts have called for urgent policy changes to cut the cost of cross-border mobile services in Africa, as the continent moves towards a seamless digital market. …
Read More »Making a new antibiotic
Two experts explain why it is so difficult ANALYSIS | ALISTAIR FARLEY & HELEN SMITH | The discovery of antibiotics is one of the greatest medical breakthroughs of the 20th century. Before antibiotics, childbirth, a urinary tract infection, or a simple cut could lead to death from infection. Antibiotics, a type …
Read More »Insurers battle to rise above climate change
Experts say incorporating ESG principles in their operations no longer an option Kampala, Uganda | ISAAC KHISA | Insurance companies have always played a crucial role in ensuring the stability of economies, offering businesses and property owners a safety net against unforeseen events. However, as climate change accelerates and its impacts …
Read More »Kasaija’s Shs72 trillion heavy budget
Experts share mixed views relating to fiscal discipline, tax, growing debt COVER STORY | JULIUS BUSINGE | As Finance Minister Matia Kasaija ascended the podium at Kololo Independence Grounds on June 13 to unveil the FY2024/2025 National Budget, the air was thick with anticipation. The nation waited with bated breath, eager …
Read More »A profitable call to entrepreneurs from oil sector experts
Kampala, Uganda | THE INDEPENDENT | Entrepreneurs have been urged to position themselves to tap into opportunities in the supply chain of the oil and gas sector. The call was made by experts during a stakeholders’ Supplier Development Workshop organized by the Stanbic Business Incubator Limited (SBIL) in Kampala on April …
Read More »Experts hail China’s role in green mobility at UNEA-6
NAIROBI, KENYA | Xinhua | The transition to green mobility, which promotes ecosystem and human health in urban centers, has accelerated, thanks to the greater availability of Chinese-manufactured new energy vehicles, said experts at the sixth session of the United Nations Environment Assembly (UNEA-6), which concluded Friday in Nairobi, the …
Read More »Dangerous chemicals found in recycled plastics
This makes them unsafe for reuse – experts explain the hazards ANALYSIS | BETHANIE CARNEY ALMROTH & ERIC CARMONA MARTINEZ | Plastic pollution is a menace worldwide. Plastics are now found in every environment on the planet, from the deepest seas to the atmosphere and human bodies. Scientific evidence describing harm …
Read More » The Independent Uganda: You get the Truth we Pay the Price
The Independent Uganda: You get the Truth we Pay the Price